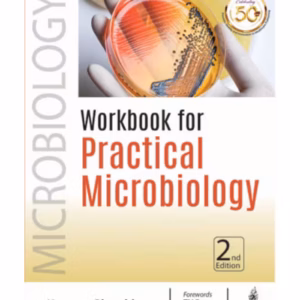

| Weight | 2.3 kg |
|---|---|
| Dimensions | 6.25 × 9.5 × 2 cm |
| Edition | 1st Edition |
| Author | Sn Tripathy |
| ISBN | 9789352703753 |
| Language | English |
| Year | 2018 |
| Binding | Paperback |
| Publisher | Jaypee Brothers Publisher |
| Pages | 82 |
Aicog Manual Of 3D Laparoscopy And Operative Oncology
₹1,029.00
30% Off
Close
Price Summary
- ₹1,475.00
- ₹1,029.00
- 30%
- ₹1,029.00
- Overall you save ₹446.00 (30%) on this product
In Stock
Highlights:
- ISBN – 9789352703753
- Author – Sn Tripathy
- Edition – 1st Edition
- Publisher – Jaypee Brothers Publisher
- Year – 2018
- Binding – Paperback
- Language – English
Ask a Question
Ask a Question
34 People viewing this product right now!
Additional information
Reviews (0)

There are no reviews yet.